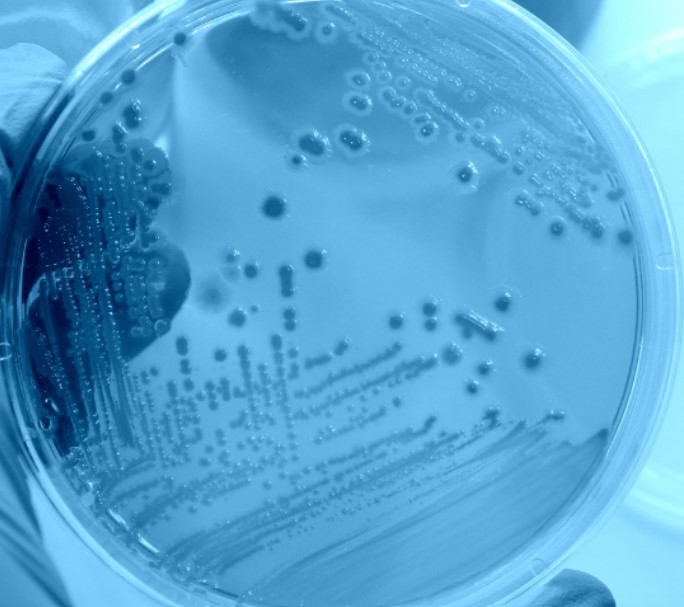
Gallery thumbnail

About
C.R. Chimica Srl opera nel settore della consulenza chimica e della chimica applicata con unesperienza ventennale, offrendo supporto qualificato alle aziende per la gestione delle problematiche ambientali, delligiene industriale e della chimica applicata. Nata dalla riorganizzazione della precedente Re.Chem.An., lazienda si occupa di analisi e consulenze su rifiuti, emissioni, suoli e acque sotterranee, scelta di sistemi per il trattamento di reflui e impianti per effluenti gassosi, controllo del gas Radon e supporto durante liter autorizzativo di nuovi impianti. Nellambito delligiene industriale, C.R. Chimica effettua valutazioni del rischio chimico attraverso campionamenti ambientali e su operatore, in conformità al D.Lgs. 81/08. Lo staff è impegnato anche nella chimica applicata, con attività che spaziano dallanalisi di giocattoli, olii alimentari e materiali a contatto con alimenti, fino allo studio di superfici riflettenti, materiali metallici e dispositivi biomedicali come gli hydrogel. Lazienda è coinvolta anche in perizie giudiziarie ambientali e consulenze tecnico-legali. Il laboratorio, situato a San Pietro Vernotico (BR), è attrezzato per svolgere tutte le attività analitiche sia in sede che in campo. C.R. Chimica è certificata ISO 9001 e sta lavorando per ottenere laccreditamento UNI EN ISO/IEC 17025.
Il nostro laboratorio, con sede a San Pietro Vernotico (BR), è dotato di strumentazioni allavanguardia per analisi di laboratorio e attività in campo.
Images